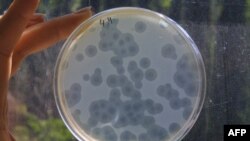

Sistik fibroz hastalığı nedeniyle 15 yaşında akciğer nakli olan İngiliz hasta, çocukluğundan beri savaştığı antibiyotiğe dirençli bakteriden, ‘faj’ adı verilen genetiği değiştirilmiş virüs terapisiyle kurtuldu.
Antibiyotiklere alternatif olabilecek ‘Bakteriyofaj’ terapisi, umut veriyor.
Daha 11 aylıkken akciğer enfeksiyonları ve nefes güçlüğüne neden olan sistik fibroz teşhisi konan Isabelle Carnell-Holdaway’in hayatı 8 yaşında vücuduna bulaşan antibiyotiğe dirençli bir bakteri nedeniyle daha da zorlaştı.
“Mycobacterium abscessus” adlı doğada bulunan mikrobakteri, sağlıklı insanları hasta etmezken, bağışıklık sistemi zaten zayıf olan Isabelle’de sürekli enfeksiyona neden oldu.
14 yaşında akciğer fonksiyonu yüzde 25’lere kadar gerileyen genç kız, 2017’nin Eylül ayında 15 yaşında çift akciğer nakli oldu ancak, ameliyattan bir süre sonra damar yoluyla verilen antibiyotikler kesilince, bakteri yeniden ortaya çıktı. Ameliyat dikişleri enfeksiyon kaptı ve kırmızıya döndü.
2018’in Ocak ayındaysa ağır karaciğer yetmezliği baş gösterdi. Londra’da yattığı hastanenin doktorları ailesine, genç kızın evine dönemeyeceğini ve yaşama şansının yüzde birden bile az olduğunu söyledi.
Deneysel tedavileri araştırmaya başlayan Isabelle’in doktoruna ‘faj terapisi’ önerisini getirense Isabel’in annesi Jo Carnell-Holdaway oldu.
Faj terapisi aslında yeni bir yöntem değil. Bakterinin doğal düşmanı olan bu virüsler, tamamen dünyaya özgü ve toprakta, deniz suyunda hatta insan bağırsağında bulunabiliyor.
Orta ve Doğu Avrupa ile Rusya’da yara enfeksiyonu, mide iltihabı, kan zehirlenmesinde hala uygulansa da geniş spektrumlu antibiyotiklerin yayılmasıyla bu terapiyi Batı tıp dünyası terketmiş.
Ancak şans bu defa Isabel’in yüzüne güldü. Zira, hastanenin mikrobiyologlarından biri tezini 20 yıl önce faj üzerine yazmıştı ve ABD’de bu konuda uzman bir bilimadamı olan Graham Hatfull’u tanıyordu.
Pittsburg Üniversitesi Biyoteknoloji Profesörü Graham Hatfull’la iletişime geçildiği gün, San Diego’da faj araştırmaları yürüten bulaşıcı hastalık uzmanı Robert Schooley de Hatfull’u ziyaret ediyordu. Görüşmeler yapıldı, Isabelle’in bakteri örneği ABD’ye gönderildi, Graham ve ekibi de bakteriyi öldürecek doğru fajları buldu.
Isabelle’in terapisi üç fajdan oluşturuldu. Hatfull ve ekibi fajlardan birinin genetiğiyle oynayarak, hedef bakterinin öldürülmesi için daha da güçlendirdi.
2018’in Nisan ayında evine gönderildiğinde beslenemediği için hızla kilo kaybeden ve yürüyemeyen genç kıza ilk faj terapisi Haziran ayında damar yoluyla enjekte edildi ve yaralarının üzerine doğrdudan uygulandı. Isabel, bir yandan da antibiyotik kullanmayı ve vücudunun yeni akciğerlerini reddetmemesi için bağışıklık baskılayıcı ilaçlarını almayı sürdürdü.
Lezyonlar iyileşmeye başladı
Önce karaciğerdeki büyük bir lezyon kayboldu. Sonra cildindeki yaralar iyileşmeye başladı. Yavaş yavaş iştahına kavuşan Isabel kilo almaya da başladı ve sonunda okuluna döndü.
Ancak mikrobakteri Isabelle’in sisteminden tamamen temizlenmiş değil. Zaman zaman cilt lezyonlarıyla kendini gösteriyor. Ailenin ve doktorların umudu uzun vadede mikrobakteriden tamamen kurtulmak.
Çalışmayı ve tedavi sürecini Nature dergisinde bir makaleyle anlatan Profesör Graham Hatfull, bu başarının hem ilk defa genetiğiyle oynanmış bir faj terapisi hem de ‘mycobacterium’u ilk defa tedavi etmiş olması nedeniyle önemli olduğuna dikkat çekti.
Faj terapisi ilaç firmalarının da gündeminde
Faj terapisinin sadece hedef bakteriye saldıracak ve vücuttaki diğer yararlı bakterilere zarar vermeyecek şekilde yaratılması büyük çaba gerektiren bir çalışma.
Büyük ilaç firmaları şimdiden potansiyel faj tedavileri için yatırımlara başladı. Genetik çalışma tekniklerinin ucuzlaması ve hızlanması, faj eczacılığının daha iyi anlaşılması ilgiyi attırsa da üretim maliyetleri hala bir soru işareti.
Üstelik bazı tıp uzmanları, eski bir Sovyet teknolojisi olması nedeniyle faj terapisinin güvenilir bir yöntem olmadığını savunuyor.